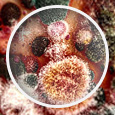

Jeżeli wiadomość jest nieczytelna, zobacz tutaj


Aktualności
 Zachęcamy do zapoznania się z Rządowym projektem ustawy o zmianie ustawy - Kodeks pracy oraz Rozporządzenia Ministra Zdrowia w sprawie substancji chemicznych, ich mieszanin, czynników lub procesów technologicznych o działaniu rakotwórczym, mutagennym lub reprotoksycznym w środowisku pracy.
Zachęcamy do zapoznania się z Rządowym projektem ustawy o zmianie ustawy - Kodeks pracy oraz Rozporządzenia Ministra Zdrowia w sprawie substancji chemicznych, ich mieszanin, czynników lub procesów technologicznych o działaniu rakotwórczym, mutagennym lub reprotoksycznym w środowisku pracy.
Projekt zmian ustawy – Kodeks pracy ma na celu nowelizację art. 222 Kodeksu pracy w zakresie rozszerzenia go na substancje reprotoksyczne oraz pozwoli na wydanie rozporządzenia przez Ministra Zdrowia, umożliwiając wdrożenie przepisów dyrektywy 2022/431 oraz objęcie ochroną pracowników pracujących w narażeniu na działanie substancji chemicznych, ich mieszanin, czynników lub procesów technologicznych o działaniu reprotoksycznym.
Konferencje
 Zapraszamy do czynnego udziału w Konferencji „Niebezpieczne substancje chemiczne a bezpieczna praca. Substancje rakotwórcze, mutagenne i reprotoksyczne” 25.09.2024 r. poprzez udział w sesji plakatowej. Sesja plakatowa została podzielona na 4 panele tematyczne:
Zapraszamy do czynnego udziału w Konferencji „Niebezpieczne substancje chemiczne a bezpieczna praca. Substancje rakotwórcze, mutagenne i reprotoksyczne” 25.09.2024 r. poprzez udział w sesji plakatowej. Sesja plakatowa została podzielona na 4 panele tematyczne:
 |
Analiza chemicznych zanieczyszczeń powietrza na stanowiskach pracy. |
 |
Ocena narażenia zawodowego związanego z występowaniem substancji chemicznych w środowisku pracy. |
 |
Ocena działania toksycznego substancji chemicznych. |
 |
Ograniczanie zagrożeń chemicznych w środowisku pracy |
Wszystkich zainteresowanych udziałem w sesji prosimy o przesłanie streszczeń do plakatów na adres email: chempyl@ciop.pl do dnia 28 czerwca 2024 r.
 Polskie Towarzystwo Higienistów Przemysłowych i Instytut Medycyny Pracy im. prof. dr med. J. Nofera zapraszają do udziału w XXIV Konferencji - Nowe wyzwania w higienie pracy, która odbędzie się w Łodzi w dniach 2-4 października 2024. Tegoroczny program konferencji obejmuje m.in. chemiczne, fizyczne i biologiczne czynniki stwarzające zagrożenie w środowisku pracy. Zgłoszenia uczestników przyjmowane będą do dn. 9 września 2024 r.
Polskie Towarzystwo Higienistów Przemysłowych i Instytut Medycyny Pracy im. prof. dr med. J. Nofera zapraszają do udziału w XXIV Konferencji - Nowe wyzwania w higienie pracy, która odbędzie się w Łodzi w dniach 2-4 października 2024. Tegoroczny program konferencji obejmuje m.in. chemiczne, fizyczne i biologiczne czynniki stwarzające zagrożenie w środowisku pracy. Zgłoszenia uczestników przyjmowane będą do dn. 9 września 2024 r.
BIOINFO
 Zbliżające się wakacje to czas podróży. Zachęcamy do odwiedzin zakładki Warto wiedzieć w bazie BIOINFO. Dostępne są tu między innymi interesujące informacje o alergiach oraz o szkodliwych czynnikach biologicznych występujących na pokładach samolotów.
Zbliżające się wakacje to czas podróży. Zachęcamy do odwiedzin zakładki Warto wiedzieć w bazie BIOINFO. Dostępne są tu między innymi interesujące informacje o alergiach oraz o szkodliwych czynnikach biologicznych występujących na pokładach samolotów.
 W majowym wydaniu miesięcznika Bezpieczeństwo Pracy - Nauka i Praktyka ukazał się artykuł „Tajemnice półmasek filtrujących. Jak sposób produkcji i użytkowania półmasek wpływa na skuteczność ich ochrony przed cząstkami biologicznymi ?” autorstwa pracowników CIOP-PIB - K. Makowskiego, M. Gołofit-Szymczak, A. Nowak i A. Brochockiej.
W majowym wydaniu miesięcznika Bezpieczeństwo Pracy - Nauka i Praktyka ukazał się artykuł „Tajemnice półmasek filtrujących. Jak sposób produkcji i użytkowania półmasek wpływa na skuteczność ich ochrony przed cząstkami biologicznymi ?” autorstwa pracowników CIOP-PIB - K. Makowskiego, M. Gołofit-Szymczak, A. Nowak i A. Brochockiej.

Zachęcamy do zapoznania się z zakresem działalności naukowej oraz ofertą badań komercyjnych Pracowni Zagrożeń Biologicznych CIOP-PIB.
Zachęcamy do zapoznania się z zakresem działalności naukowej oraz ofertą badań komercyjnych Pracowni Zagrożeń Biologicznych CIOP-PIB.
###UNSUBSCRIBE_NOTE###




